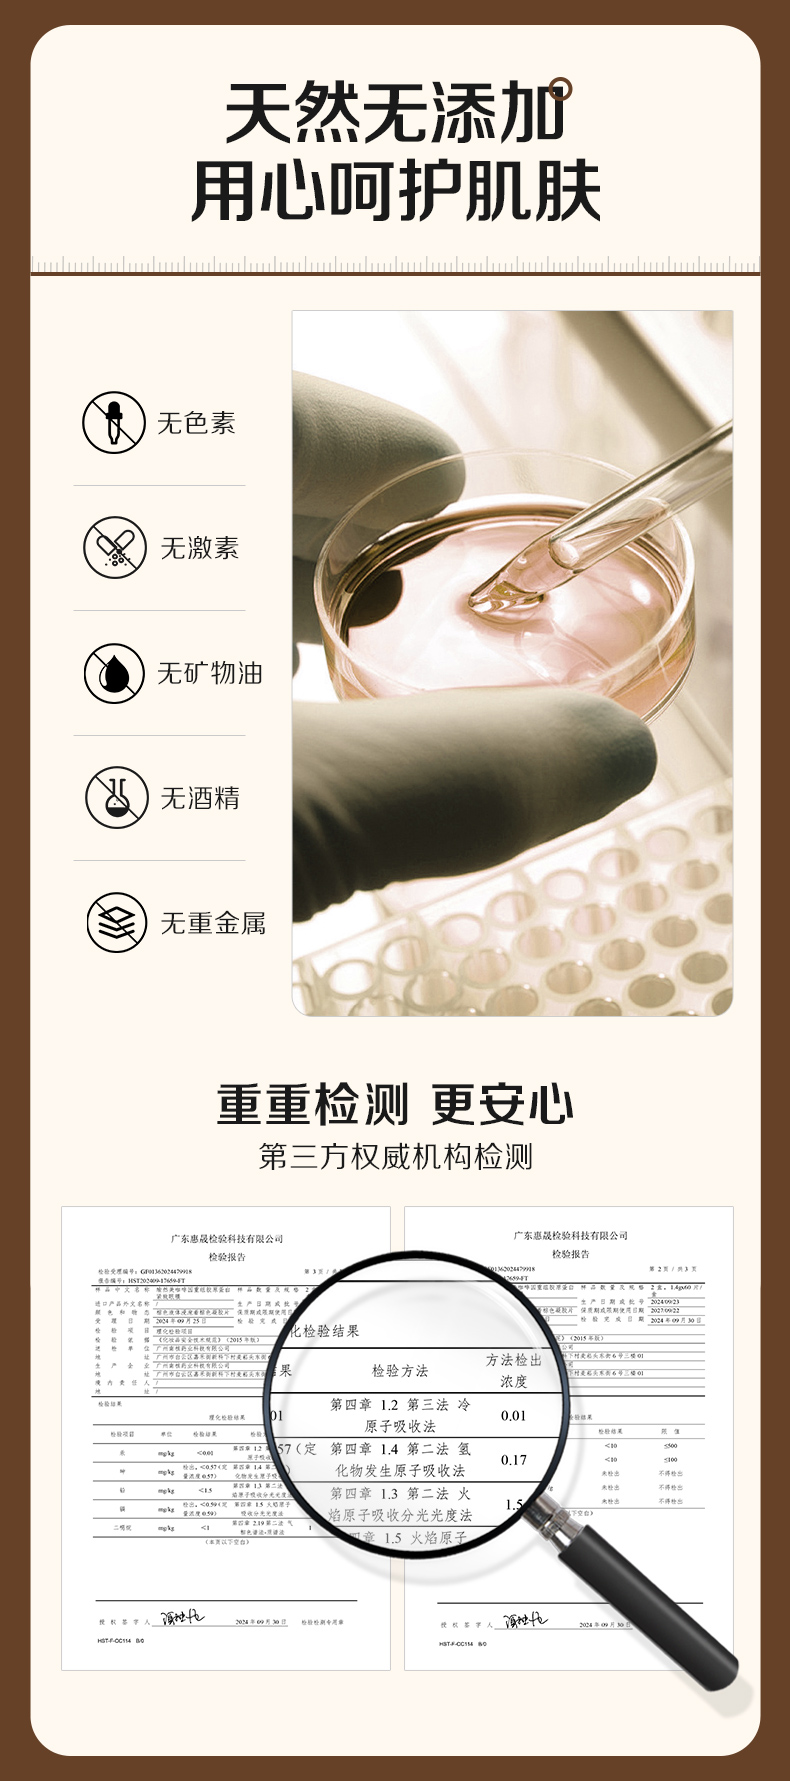

瑜然美咖啡因重组胶原蛋白紧致眼膜补水保湿提拉紧致抗皱淡纹细纹眼干
¥59.90 - 99.90
| 运费: | ¥ 0.00-18.00 |
| 库存: | 898 件 |
商品详情

- 瑜然美SPA美妆商城200511 (微信公众号认证)
- 美妆护肤
- 扫描二维码,访问我们的微信店铺
- 随时随地的购物、客服咨询、查询订单和物流...